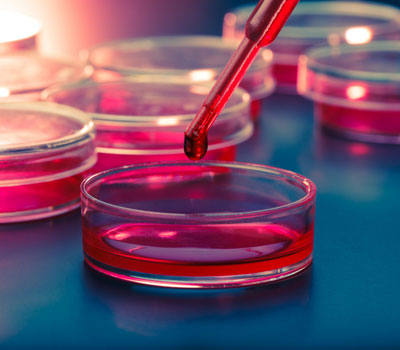
stem-cell-therapy

Stem cellular therapy in kurnool uses unspecialized cells or cells that aren't assigned a format yet. Cells commonly are specialized. For instance, they might be liver, brain cells or nerve cells. They have a fixed characteristic inside the body.
Their unassigned fact makes them doubtlessly useful in healing. The concept is that by injecting stem cells into an injury by best doctors for stem cell therapy in kurnool, they may become the cells wanted to restore. Stem cells injected at stem cell therapy clinics in Kurnool right into a knee with torn cartilage may additionally develop into cartilage cells.

Lotus Advanced Skin Laser & Hair Transplant Centre is the best hospitals for stem cell therapy in Kurnool who never compromise with quality of skin and hair treatment and patient's safety.
Stem cellular therapy in kurnool uses unspecialized cells or cells that aren't assigned a format yet. Cells commonly are specialized. For instance, they might be liver, brain cells or nerve cells. They have a fixed characteristic inside the body.
Their unassigned fact makes them doubtlessly useful in healing. The concept is that by injecting stem cells into an injury by best doctors for stem cell therapy in kurnool, they may become the cells wanted to restore. Stem cells injected at stem cell therapy clinics in Kurnool right into a knee with torn cartilage may additionally develop into cartilage cells.
Lotus Advanced Skin Laser & Hair Transplant Centre is the best hospitals for stem cell therapy in Kurnool who never compromise with quality of skin and hair treatment and patient's safety.